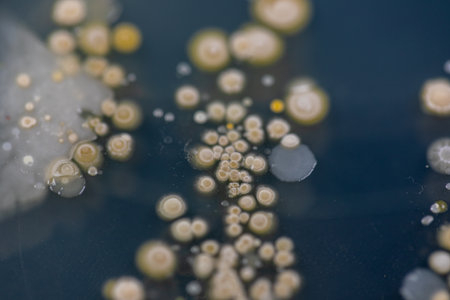
Backgrounds of Characteristics and Different shaped Colony of Bacteria and Mold growing on agar plates from Soil samples for education in Microbiology laboratory.の写真素材

写真素材 - Backgrounds of Characteristics and Different shaped Colony of Bacteria and Mold growing on agar plates from Soil samples for education in Microbiology laboratory.
作品情報
Backgrounds of Characteristics and Different shaped Colony of Bacteria and Mold growing on agar plates from Soil samples for education in Microbiology laboratory.
- ID:169161163
- 作品種別:写真
- 作者名:sinhyu
キーワード
- actinomyces
- agar
- analysis
- background
- bacteria
- bacterial
- bacterium
- biology
- biotechnology
- characteristic
- colony
- culture
- danger
- disease
- dish
- education
- environment
- equipment
- experiment
- food
- fungi
- germs
- growing
- growth
- health
- health care
- hygiene
- identification
- isolated
- lab
- laboratory
- medical
- medicine
- micro
- microbial
- microbiology
- microorganism
- mold
- molds
- organism
- pattern
- petri
- plate
- research
- risk
- safety
- sample
- samples
- science
- shape
- soil samples
- species
- texture
- white
- yeast
類似作品
Geometric shape...
minimalist and ...
3d rendering of...
3d rendering of...
A vibrant close...
Abstract backgr...
Chalkboard fill...
A captivating a...
A warning trian...
An abstract and...
Close-up of sha...
stone texture b...
Colorful abstra...
3d rendering of...
Stairs ascendin...
This image show...
An abstract bac...
Abstract blue a...
Close-up view o...
Geometric shape...
A modern 3D wal...
Shattered plast...
abstract backgr...
Fabric texture,...
Concept illustr...
3d rendering of...
Abstract backgr...
Fantasy alien p...
A vibrant abstr...
Concrete Patter...
leaf texture
A wooden shelf ...
3d rendering of...
Abstract backgr...
Multicolored ab...
Colorful pebble...
Geometric block...
Dynamic wooden ...
A tree leaf ove...
Concrete backgr...
Vibrant teal ab...
Abstract backgr...
colored backgro...
Colorful geomet...
shadow on white...
Top view of bla...
Sunlight throug...